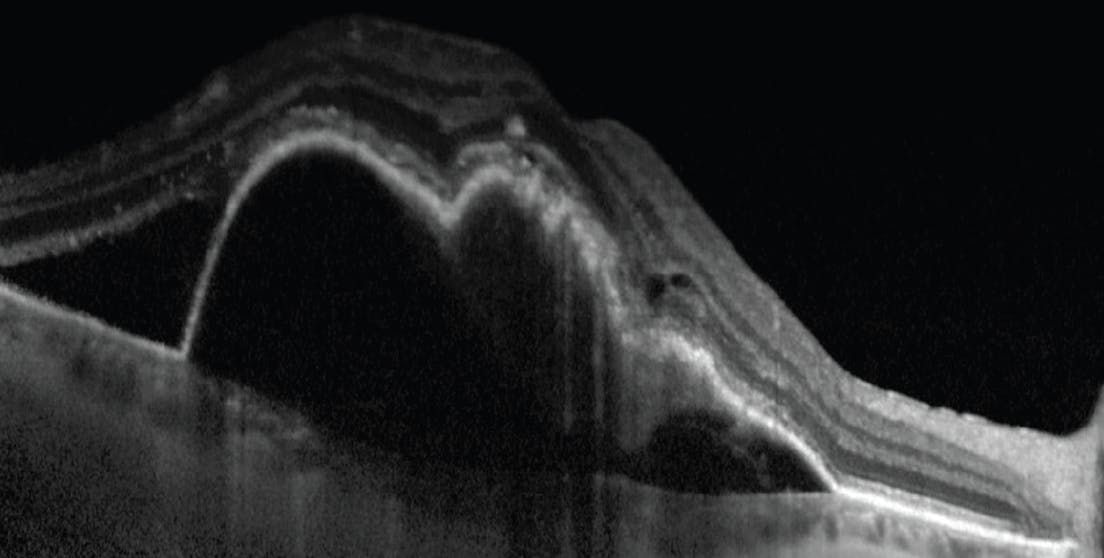

AT A GLANCE
- An alternative target for several wet AMD drug candidates is the tyrosine kinase pathway.
- Other drugs in the pipeline use vector-based gene therapy with the goal of administering one injection to provide sustained intraocular expression of an anti-VEGF protein.
- Therapeutics in phase 3 include OPT-302 (Opthea), KSI-301 (Kodiak Sciences), RGX-314 (Regenxbio) subretinal injection, and BAT5906 (Bio-thera).
Although intravitreal anti-VEGF injections have revolutionized our approach to wet AMD, roughly 20% of patients still lose vision and less than half achieve a VA of 20/40 despite ongoing injections (Figure).1-3 In addition, the initial visual gains seen in clinical trials are often not maintained long-term. Disappointing real-world outcomes may, in part, be the result of undertreatment due to a high treatment burden.4 Thus, researchers are working to extend the treatment duration of our tried-and-true therapies. In the vein of longer duration therapy, the FDA approved both the port delivery system with ranibizumab (Susvimo, Genentech/Roche) and intravitreal faricimab (Vabysmo, Genentech/Roche) for the treatment of wet AMD. More recently, Regeneron reported results of the use of 8 mg aflibercept for wet AMD from the phase 3 Pulsar trial, in which 79% of study patients maintained 12-week dosing on high-dose aflibercept at 48 weeks, and 77% maintained a 16-week dosing regimen.5
Figure. OCT imaging of a patient with wet AMD in the right eye demonstrates macular edema, subretinal fluid, and a large pigment epithelial detachment.
Outside of the traditional anti-VEGF space, several other innovations are under investigation, including alternative delivery mechanisms, new targetable molecules, extended-duration drug formulations, and biosimilars that may provide identical safety and efficacy at lower prices (Table).
TYROSINE KINASE INHIBITORS
An alternative targeted for several wet AMD drug candidates is the tyrosine kinase pathway. When VEGF binds to its receptor, it initiates a tyrosine kinase cascade that allows tyrosine kinase inhibitors (TKI) to affect all members of the VEGF family of molecules.6
Sunitinib maleate (GB-102, GrayBug Vision) is a TKI delivered via intravitreal injection twice a year. ALTISSIMO, the phase 2b trial, showed similar central subfield thickness but lower BCVA than patients treated with bimonthly aflibercept (Eylea, Regeneron; NCT03953079).7
Another TKI in phase 2 is D-4517.2 (Ashvattha Therapeutics), a sunitinib analog that is injected subcutaneously every month (NCT05387837).
Axitinib (CLS-AX, Clearside Biomedical) is a TKI that is delivered via suprachoroidal injection (NCT04626128). The phase 1/2a OASIS trial met its primary endpoint at 3 months, with a favorable safety profile and a 73% reduction in the treatment burden for cohorts 3 and 4.8
Vorolanib (EYP-1901, EyePoint Pharmaceuticals), is a TKI that uses the company’s sustained intraocular delivery platform, Durasert. The phase 2 DAVIO 2 trial dosed its first patient in August and will be assessing two dosage arms compared with aflibercept (NCT05381948).9
GENE THERAPY
Other drugs in the pipeline use gene therapy with the goal of administering one injection to provide sustained expression of an anti-VEGF protein.10
Ixoberogene soroparvovec (Ixo-vec [formerly ADVM-022], Adverum Biotechnologies) completed the phase 1 OPTIC trial, showing that one intravitreal injection of the study drug led to robust intraocular expression of an aflibercept-like protein that was comparable with standard anti-VEGF injection therapy over 24 weeks (NCT03748784).11 The phase 2 LUNA trial launched with the first patient dosed in September (NCT05536973).12
PHASE 1 TRIALS TO WATCH
- OTX-TKI (Ocular Therapeutix), an intravitreal implant that releases the TKI axitinib, is currently in a phase 1 trial with final results pending (NCT03630315). Interim safety and efficacy data, presented at AAO 2022, indicated that 80% of study subjects were rescue-free up to 6 months.
- BD311 (BDgene Co) is a suprachoroidal gene therapy that increases VEGF-A antibody expression in retinal pigment epithelium cells to neutralize VEGF activity and decrease retinal angiogenesis. The company is recruiting for a phase 1 trial (NCT05099094).
- AIV007 (AiViva BioPharma), an intravitreally administered gel suspension that targets VEGFR, PDGFR, and FGFR and modulates TGFΒ1 mRNA expression and TGFΒ1 levels, completed phase 1 with results pending (NCT04422899).
- AR-13503 (Aerie) is a rho-associated protein kinase inhibitor sustained-release intravitreal implant with phase 1 results pending (NCT03835884).
- ASKG712 (AskGene Pharma) is an anti-VEGF antibody/angiopoietin 2 antagonist peptide fusion protein delivered via intravitreal injection. The company has not started recruitment for its phase 1 trial (NCT05456828).
- RO7250284 (Hoffmann-La Roche) is a bispecific human antigen-binding fragment form of faricimab delivered via a port delivery system. The company is currently recruiting for a phase 1 trial (NCT04567303).
- MHU650 (Novartis), administered as a single intravitreal injection, completed a phase 1 single ascending dose study with results pending (NCT04635800).
- HMR59 (Hemera Biosciences/Janssen Pharmaceuticals) is an AAV2 vector gene therapy that is delivered via a single intravitreal injection. The phase 1 proof-of-concept study is complete with data pending (NCT03585556).
4D-150 (4D Molecular Therapeutics) is a dual-transgene intravitreal gene therapy designed to inhibit four angiogenic factors. A one-time dose of 4D-150 will be compared with regularly dosed aflibercept injections in a phase 1/2 trial that is currently recruiting (NCT05197270). This gene therapy codes for an aflibercept-like protein and a small inhibiting RNA that blocks VEGF-C.
RGX-314 (Regenxbio) is a gene therapy that uses adeno-associated vector 8 that promotes native production of a ranibizumab-like protein as an attempted one-time treatment for wet AMD. In the phase 2 AAVIATE trial, RGX-314 is delivered suprachoroidally via a microinjector (Clearside Biomedical) at various doses. Regenxbio announced complete enrollment of cohort 5 of the study in July.13
RGX-314 is also being delivered as a subretinal injection in two phase 3 trials, ASCENT (NCT05407636) and ATMOSPHERE (NCT04704921), that are comparing two dosing arms of RGX-314 with intravitreal ranibizumab (Lucentis, Genentech/Roche) or aflibercept. In both trials, which are currently enrolling, eyes undergo pars plana vitrectomy to allow intraoperative access to the subretinal space.
A ONE-TWO (OR THREE) PUNCH
Several therapeutics are targeting multiple pathways. OPT-302 (Opthea) is a Fc-fusion protein designed to inhibit VEGF-C and VEGF-D. In the phase 2b trial, OPT-302 with ranibizumab had a significant increase in BCVA at 24 weeks compared with ranibizumab monotherapy (NCT03345082).14 Two phase 3 trials, ShORe (NCT04757610) and COAST (NCT04757636), are currently recruiting.
IBI302 (Innovent Biologics) is a recombinant human anti-VEGF and anticomplement (C3b and C4b) bispecific fusion protein in a phase 2 trial.15 The study compares IBI302 dosed every 8 or 12 weeks with aflibercept dosed monthly (NCT05403749). The phase 1 trial showed improved visual function and good tolerability after 6 weeks of injection.16
ALTENATIVE PATHWAYS
UBX1325 (Unity Biotechnology) is a small molecule Bcl-xL inhibitor that increases apoptosis of diseased senescent cells in the retinal pigment epithelium, subsequently suppressing inflammation and neovascularization.17 The company announced in September that enrollment is complete for its phase 2 ENVISION trial (NCT05275205).
AXT107 (Asclepix Therapeutics) works on the Tie-2 signaling pathway and is designed to be a yearly intravitreal self-assembling depot. The phase 1/2a study of 18 patients is complete with data pending (NCT04746963).
RBM-007 (Ribomic) is anti-fibroblast growth factor 2 aptamer that inhibits angiogenesis and scar formation. Initial results from the phase 2 trial, TEMPURA, in which study eyes received a single intravitreal injection of RBM-007, suggests that it has the potential to improve BCVA in treatment-naive wet AMD eyes (NCT04895293).
Tarcocimab (KSI-301, Kodiak Sciences) uses a new antibody biopolymer conjugate platform. The biopolymer attached to the antibody binds to VEGF, increasing the size of the molecule and allowing for a higher concentration and longer effect duration. Although the phase 2b/3 DAZZLE trial did not meet the primary efficacy endpoint (NCT04049266), the phase 3 DAYLIGHT trial is evaluating tarcocimab dosed every 4 weeks compared with aflibercept every 8 weeks (NCT04964089).18
BAT5906 (Bio-thera) is a recombinant anti-VEGF intravitreal injection being compared with aflibercept in a phase 3 trial that is not yet recruiting (NCT05439629).
TOPICAL AND ORAL OPTIONS
PAN-90806 (PanOptica) is a topical VEGFR2 TKI drop. A completed phase 1/2 showed 51% of patients on PAN-90806 were able to complete the study with no rescue injections and demonstrated anti-VEGF biological response at all doses tested (NCT03479372).
Topical MG-O-1002 (Theratocular Biotek) is currently being evaluated for safety compared with placebo in a phase 2 trial that has yet to start recruiting (NCT05390840).
Oral AKST4290 (Alkahest) inhibits chemokine C-C motif receptor 3. AKST2490 is dosed twice daily after three initial loading doses of aflibercept (NCT04331730). Results are pending from the completed phase 2 trial.
BIOSIMILARS UNDER INVESTIGATION
Xlucane (Xbrane Biopharma AB), GNR-067 (AO Generium), and LUBT010 (Lupin) are ranibizumab biosimilars in phase 3 trials. Aflibercept biosimilars in phase 3 trials include ALT-L9 (Alteogen),19 ABP-938 (Amgen, Parexel), AVT06 (Alvotech), FYB203 (Formycon, Bioeq), SOK583A19 (Sandoz), and SCD411 (Sam Chun Dang Pharm Co).20,21
ONS-5010 (Outlook Therapeutics) and TAB014 (TOT Biopharm) are bevacizumab (Avastin, Genentech/Roche) biosimilars in phase 3 trials. The FDA accepted Outlook Therapeutics’ biologics license application for ONS-5010 in October with the hope for market approval in 2023.22
THAT’S A WRAP
In today’s treatment landscape, poor visual outcomes in wet AMD are exacerbated by the high treatment burden of current therapies. Given the large number of clinical trials evaluating novel therapies for wet AMD, there is promise that alternative, more sustainable and effective treatments for the disease are on the horizon.
1. Modi YS, Tanchon C, Ehlers JP. Comparative safety and tolerability of anti-VEGF therapy in age-related macular degeneration. Drug Saf. 2015;38(3):279-293.
2. Ciulla TA, Huang F, Westby K, Williams DF, Zaveri S, Patel SC. Real-world outcomes of anti-vascular endothelial growth factor therapy in neovascular age-related macular degeneration in the United States. Ophthalmol Retina. 2018;2(7):645-653.
3. Ciulla TA, Hussain RM, Pollack JS, Williams DF. Visual acuity outcomes and anti-vascular endothelial growth factor therapy intensity in neovascular age-related macular degeneration patients: a real-world analysis of 49 485 eyes. Ophthalmol Retina. 2020;4(1):19-30.
4. Mones J, Singh RP, Bandello F, et al. Undertreatment of neovascular age-related macular degeneration after 10 years of anti-vascular endothelial growth factor therapy in the real world: the need for a change of mindset. Ophthalmologica. 2020;243(1):1-8.
5. Aflibercept 8 mg meets primary endpoints in two global pivotal trials for DME and Wet AMD for 12- and 16-week dosing [press release]. Eyewire+. September 8, 2022. Accessed October 4, 2022. eyewire.news/news/aflibercept-8-mg-meets-primary-endpoints-in-two-global-pivotal-trials-for-dme-and-wet-amd-for-12-and-16-week-dosing
6. Gotink KJ, Verheul HM. Anti-angiogenic tyrosine kinase inhibitors: what is their mechanism of action? Angiogenesis. 2010;13(1):1-14.
7. Graybug Vision reports full-data analysis from 12-month treatment phase of ALTISSIMO phase 2b trial in wet AMD [press release]. Global NewsWire. May 12, 2021. Accessed September 15, 2022. globenewswire.com/en/news-release/2021/05/12/2228005/0/en/Graybug-Vision-Reports-Full-Data-Analysis-from-12-Month-Treatment-Phase-of-ALTISSIMO-Phase-2b-Trial-in-Wet-AMD.html
8. Clearside Biomedical announces positive results in safety, durability and biologic effect in OASIS phase 1/2a clinical trial of suprachoroidal CLS-AX (axitinib injectable suspension) in wet AMD patients [press release]. Clearside Biomedical. November 9, 2022. Accessed November 10, 2022. ir.clearsidebio.com/news-releases/news-release-details/clearside-biomedical-announces-positive-results-safety
9. EyePoint Pharmaceuticals announces first patient dosed in phase 2 DAVIO 2 clinical trial [press release]. Eyewire+. August 1. 2022. Accessed September 15, 2022. eyewire.news/news/eyepoint-pharmaceuticals-announces-first-patient-dosed-in-phase-2-davio-2-clinical-trial-of-eyp-1901-for-the-maintenance-treatment-of-wet-amd
10. Guimaraes TAC, Georgiou M, Bainbridge JWB, Michaelides M. Gene therapy for neovascular age-related macular degeneration: rationale, clinical trials and future directions. Br J Ophthalmol. 2021;105(2):151-157.
11. Adverum presents data showing gene therapy maintained efficacy, durability, safety in wet AMD patients [press release]. October 1, 2021. Accessed September 15, 2022. eyewire.news/news/adverum-data-shows-gene-therapy-maintained-efficacy-durability-safety-in-wet-amd-patients
12. Adverum Biotechnologies announces first subject dosed with Ixo-vec in the phase 2 LUNA trial for the treatment of wet age-related macular degeneration [press release]. Adverum Biothechnologies. September 14, 2022. Accessed September 15, 2022. investors.adverum.com/news/news-details/2022/Adverum-Biotechnologies-announces-first-subject-dosed-with-Ixo-vec-in-the-phase-2-LUNA-trial-for-the-treatment-of-wet-age-related-macular-Ddegeneration/default.aspx
13. Regenxbio announces enrollment complete in cohort 5 of phase II AAVIATE trial [press release]. Regenxbio. July 8, 2022. Accessed September 15, 2022. regenxbio.gcs-web.com/news-releases/news-release-details/regenxbio-announces-enrollment-complete-cohort-5-phase-ii
14. Wet AMD trials phase 2. Opthea. Accessed September 15, 2022. opthea.com/wet-amd-clinical-trial
15. Ren X, Li J, Xu X, Wang C, Cheng Y. IBI302, a promising candidate for AMD treatment, targeting both the VEGF and complement system with high binding affinity in vitro and effective targeting of the ocular tissue in healthy rhesus monkeys. Exp Eye Res. 2016;145:352-358.
16. Wang F, Sun X, Shujie Lu S. A multidose phase 1b study of IBI302 in patients with neovascular AMD. Presented at AAO 2021; November 12, 2021; New Orleans, LA.
17. Crespo-Garcia S, Tsuruda PR, Dejda A, et al. Pathological angiogenesis in retinopathy engages cellular senescence and is amenable to therapeutic elimination via BCL-xL inhibition. Cell Metab. 2021;33(4):818-832e817.
18. Stern HD, Hussain RM. KSI-301: an investigational anti-VEGF biopolymer conjugate for retinal diseases. Expert Opin Invest Drugs. 2022;31(5):443-449.
19. Clinical study of ALT-L9 to determine safety, efficacy and pharmacokinetics in neovascular AMD. Accessed September 15, 2022. clinicaltrials.gov/ct2/show/NCT04058535
20. Kapur M, Nirula S, Naik MP. Future of anti-VEGF: biosimilars and biobetters. Int J Retina Vitreous. 2022;8(1):2.
21. Novartis’ Sandoz unit confirms late-stage clinical development plans for proposed biosimilar aflibercept [press release]. Eyewire+. May 4, 2021. Accessed September 15, 2022. eyewire.news/articles/novartis-sandoz-unit-confirms-late-stage-clinical-development-plans-for-proposed-biosimilar-aflibercept
22. Outlook Therapeutics announces acceptance of BLA by FDA for ONS-5010 as a treatment for wet AMD [press release]. Eyewire+. October 28, 2022. Accessed November 4, 2022. eyewire.news/news/outlook-therapeutics-announces-acceptance-of-biologics-license-application-by-fda-for-ons-5010-as-a-treatment-for-wet-amd


































